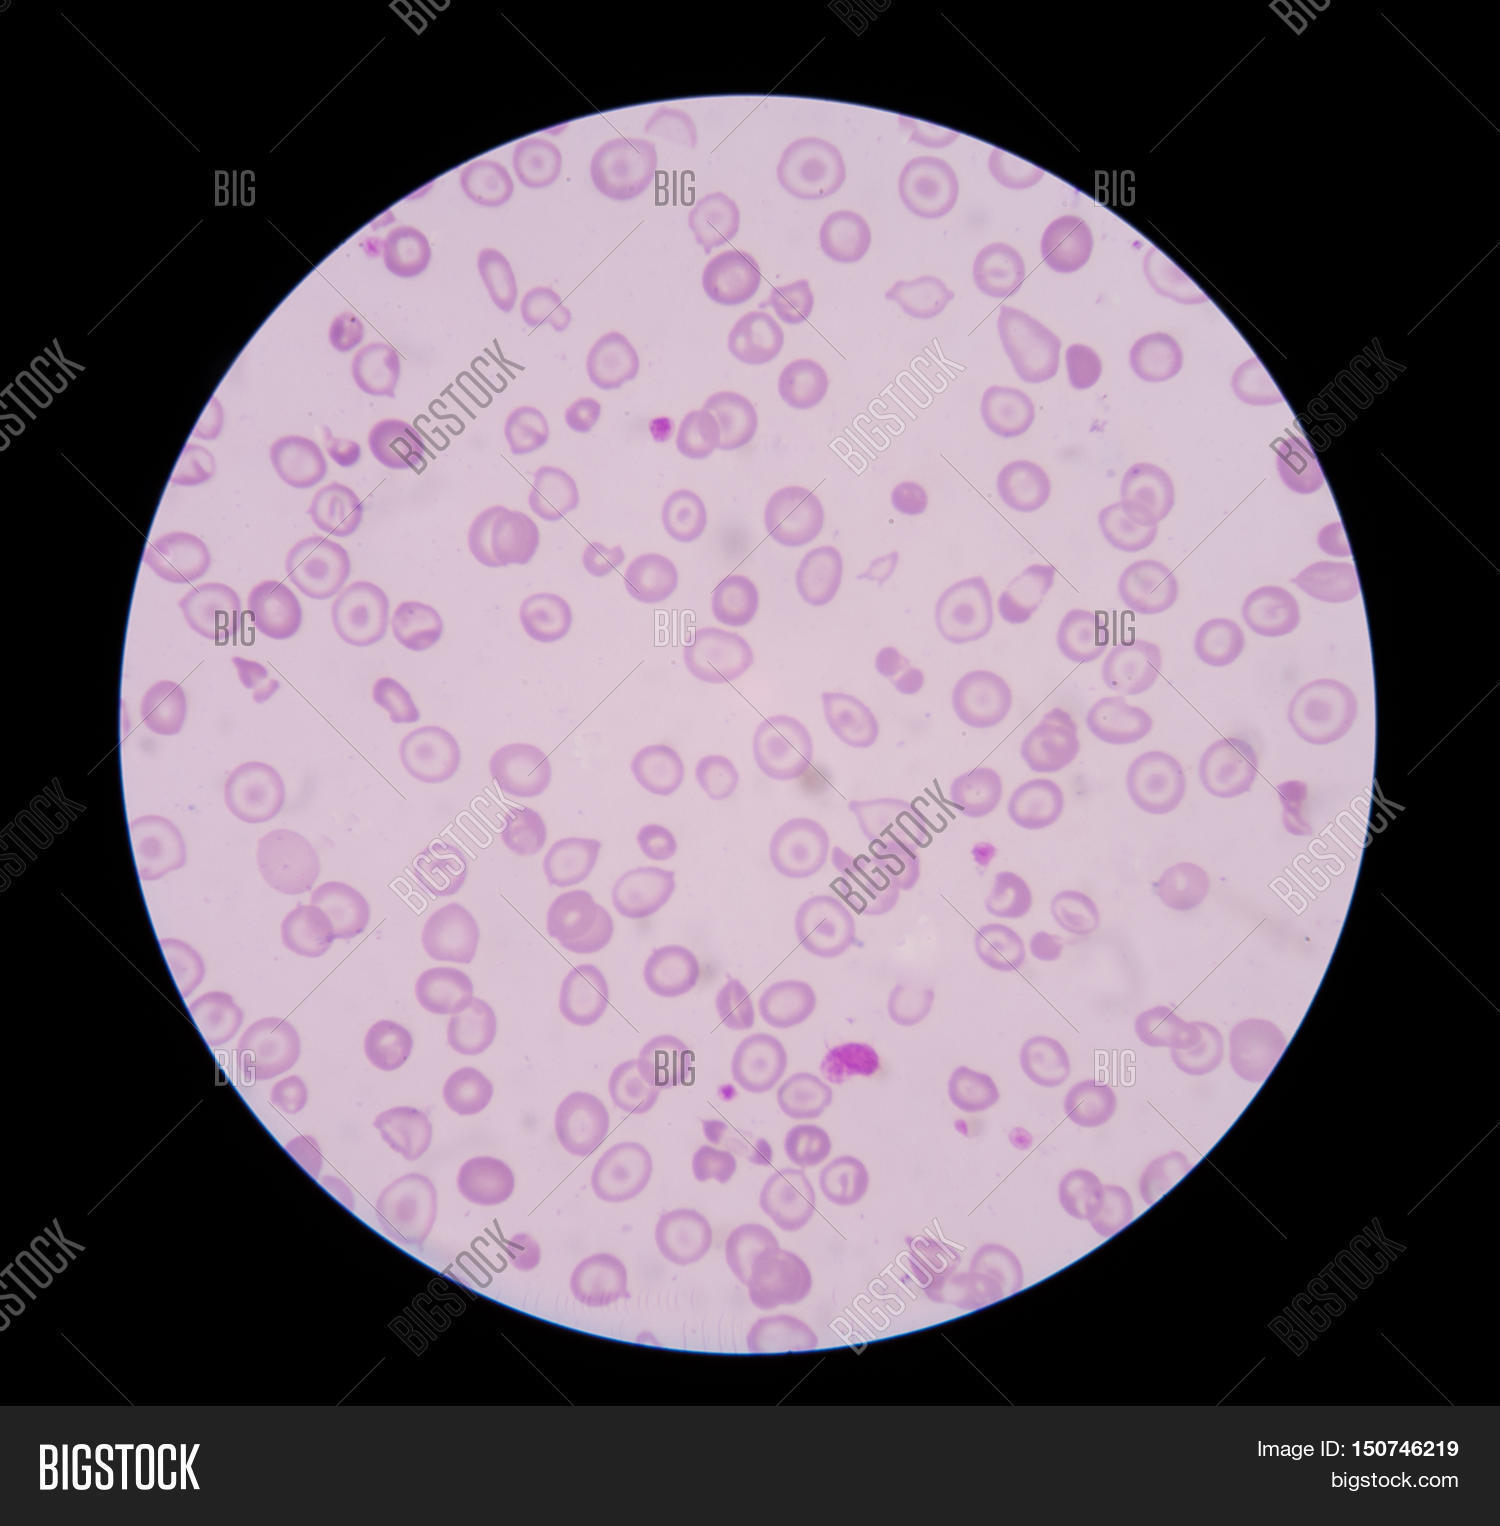

Микроцитоз 3
Координаты объекты 5 класс география
Вавада 754
Гибкая подводка 90
Комикс crazy dad 3d
Напишите небольшое сочинение в котором
Сытин настрои для женщин суставы
Автобус уссурийск краскино
Бесплатные блютуз наушники
Слова маркеры с переводом
My one and only friend
Маскарадный плащ 6
Kt 519
Разложения солнечного света в спектр
Микроцитоз 3 108 фото